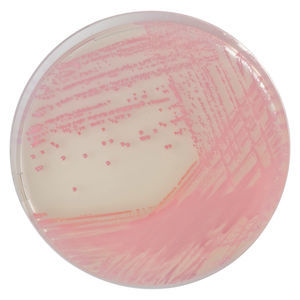

- Laboratorio >
- Medicina del laboratorio >
- Reactivo de Staphylococcus aureus
Reactivos de Staphylococcus aureus
& encuentre a todos sus clientes en un solo lugar durante todo el año
Hacerse expositor{{product.productLabel}} {{product.model}}
{{#if product.featureValues}}{{product.productPrice.formattedPrice}} {{#if product.productPrice.priceType === "PRICE_RANGE" }} - {{product.productPrice.formattedPriceMax}} {{/if}}
{{#each product.specData:i}}
{{name}}: {{value}}
{{#i!=(product.specData.length-1)}}
{{/end}}
{{/each}}
{{{product.idpText}}}
{{product.productLabel}} {{product.model}}
{{#if product.featureValues}}{{product.productPrice.formattedPrice}} {{#if product.productPrice.priceType === "PRICE_RANGE" }} - {{product.productPrice.formattedPriceMax}} {{/if}}
{{#each product.specData:i}}
{{name}}: {{value}}
{{#i!=(product.specData.length-1)}}
{{/end}}
{{/each}}
{{{product.idpText}}}

Temperatura de almacenamiento: -18 °C
... Información sobre el patógeno Los Staphylococcus aureus son bacterias cocos grampositivas que se encuentran en todas partes en el medio ambiente. Alrededor del 25-30 % de la población humana es portadora ...

Temperatura de almacenamiento: -18 °C
... El virellaPRRSV real time RT-PCR Kit es un ensayo para la detección simultánea del ARN de la cepa norteamericana (NA), europea (EU) y altamente patógena (HP) del genotipo NA del virus del síndrome respiratorio y reproductivo porcino (PRRSV). ...

... Tamaño del envase: 4x3ml Plazo de entrega: Aproximadamente dos semanas desde la recepción del pedido Esta mezcla no está clasificada como peligrosa según el SGA. ...

Temperatura de almacenamiento: 2 °C - 8 °C
... lámina y una cubierta transparente sobre el medio. medio. El método Easy Plate SA está destinado a indicar el nivel de Staphylococcus aureus en los productos alimenticios. Es compacto y fácil de usar ...

Temperatura de almacenamiento: -70 °C - -20 °C
Pureza: 99 % - 99 %
... La membrana basal es una matriz situada bajo la superficie basal de las células epiteliales de los animales. Scilia Extragel Matrix es un hidrogel de matriz reconstituida formado por componentes de la membrana basal extraídos de tejidos ...


reactivo gel de agarINTRAY® MUELLER-HINTON
Temperatura de almacenamiento: 2 °C - 8 °C
... Agilice su flujo de trabajo con InTray Mueller Hinton Chocolate Agar. Tanto si se utiliza en el laboratorio como en el punto de necesidad, ahora puede combinar la recogida, el transporte, el crecimiento y el resultado en un solo dispositivo. ...
Temperatura de almacenamiento: 15, 30, 2, 8 °C
... medio de cultivo cromogénico selectivo y diferencial para la detección cualitativa directa de la colonización por Staphylococcus aureus resistente a la meticilina (SARM) para ayudar en la prevención ...
CHROMagar

Temperatura de almacenamiento: 2 °C - 8 °C


medio reactivo02001
... El agar Baird Parker es un medio gelatinoso selectivo para el aislamiento y recuento de Staphylococcus aureus en alimentos. Recipiente placas de Petri de 90 mm Envase 5x2x placas de Petri de 90 mm (bolsa ...
RTA Laboratories
& encuentre a todos sus clientes en un solo lugar durante todo el año
Hacerse expositorSus sugerencias de mejora:
a los mejores proveedores
¡Suscríbase a nuestra Newsletter!
Recibirá todas las novedades de esta sección cada mes
Consulte nuestra Política de Confidencialidad para conocer cómo MedicalExpo trata sus datos personales
- Lista de marcas
- Cuenta de Fabricante
- Cuenta de Comprador
- Nuestros servicios
- Inscripción newsletter
- Acerca de VirtualExpo Group
¿Cuáles?
Ayúdenos a mejorar:
caracteres restantes